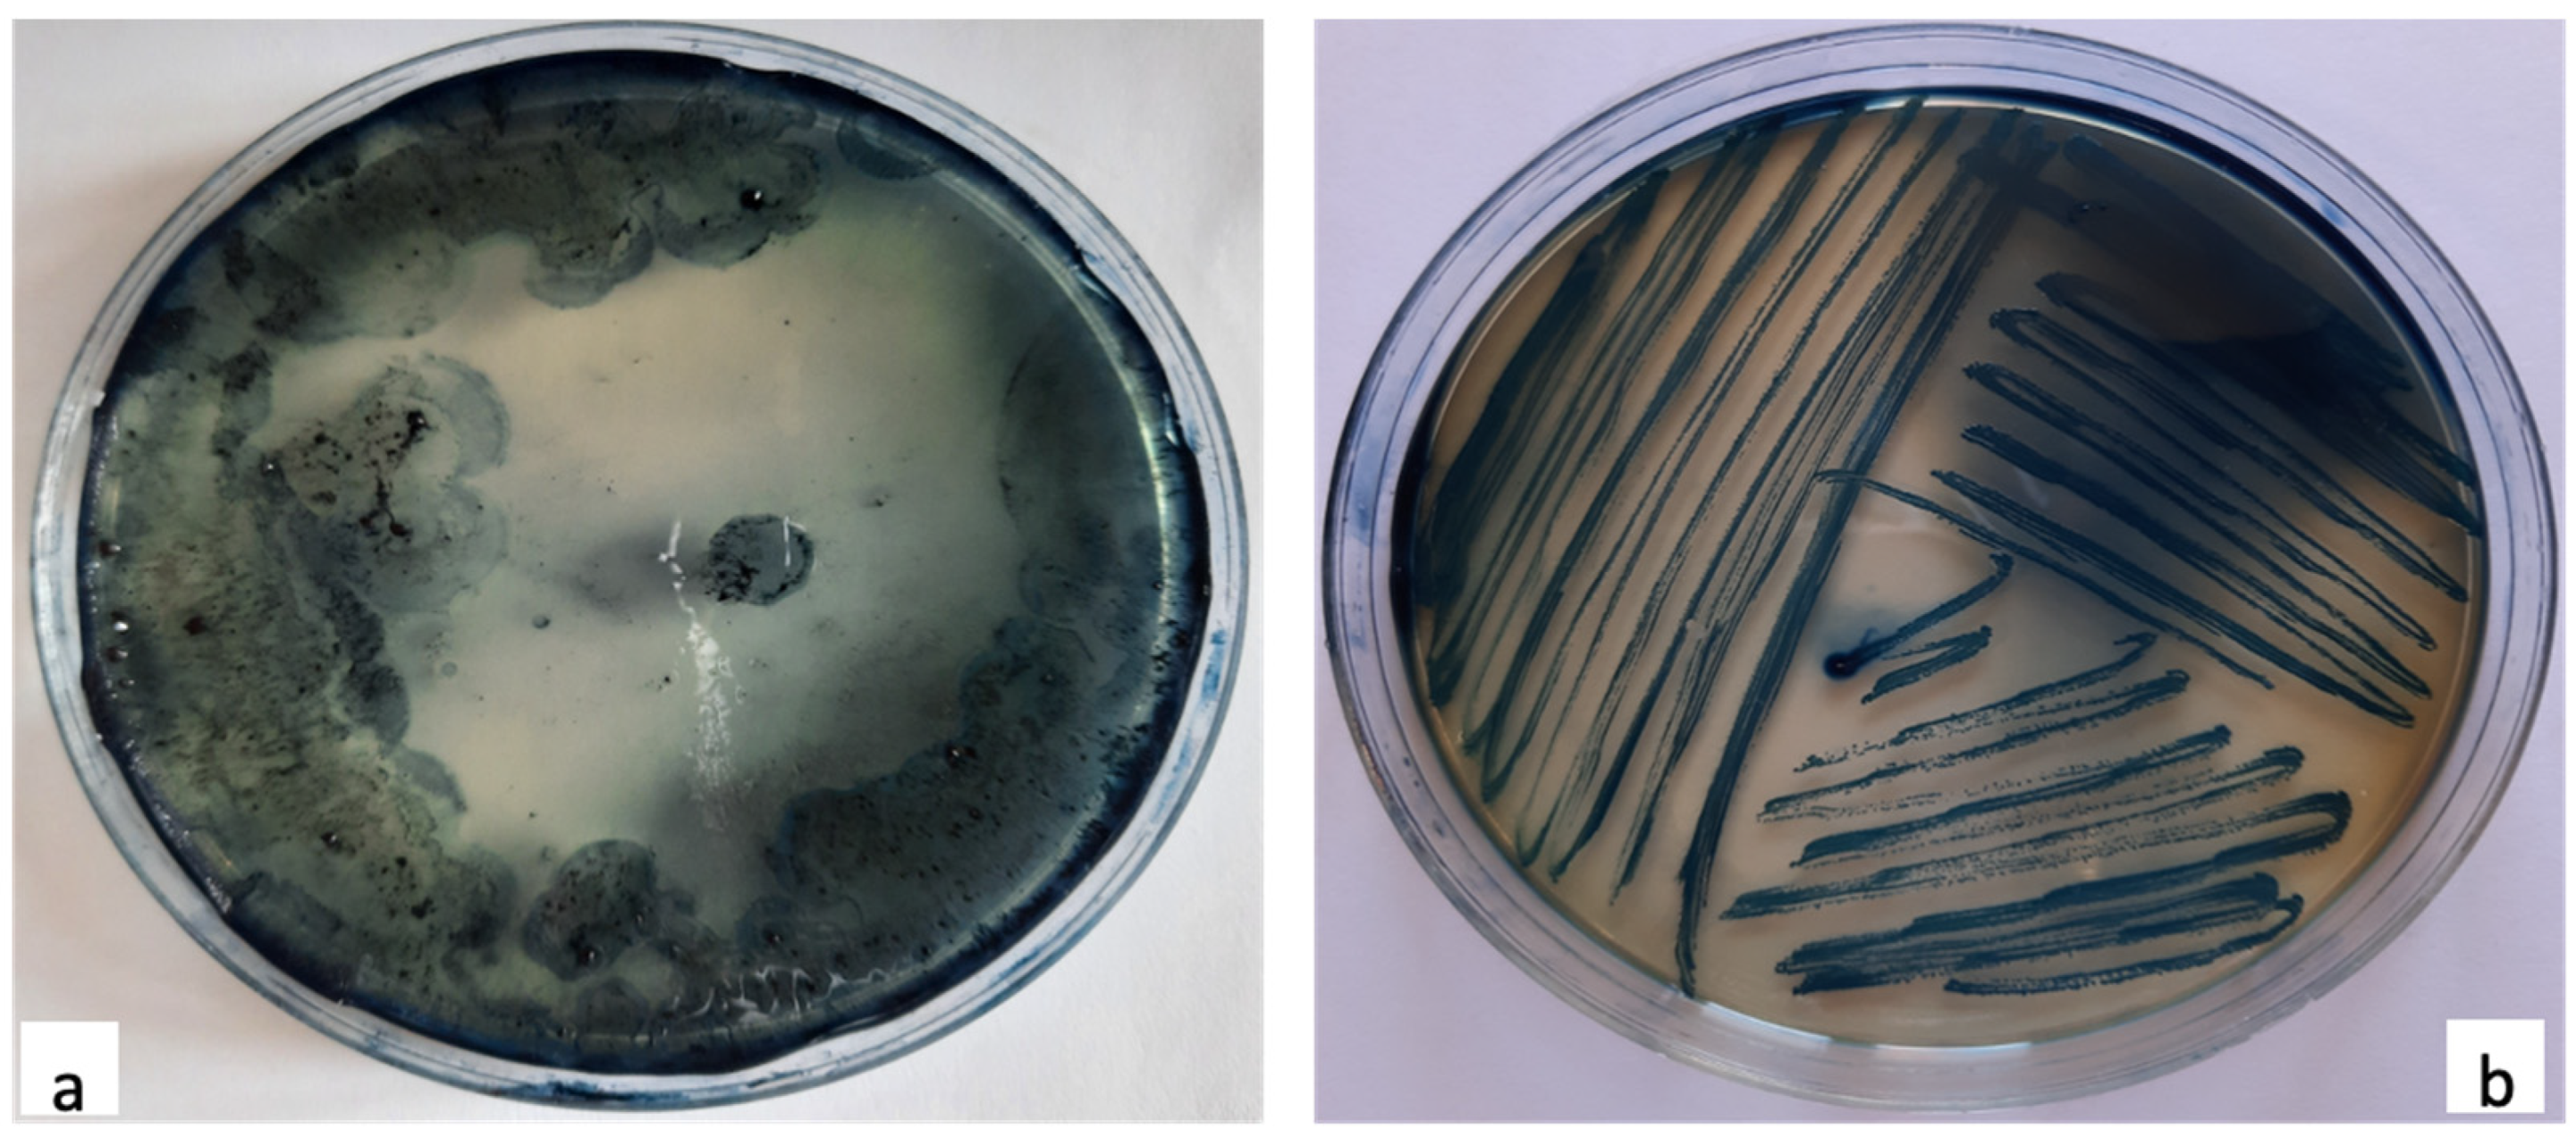
Polymers 13 01870 g003 Polymers 13 01870 g003
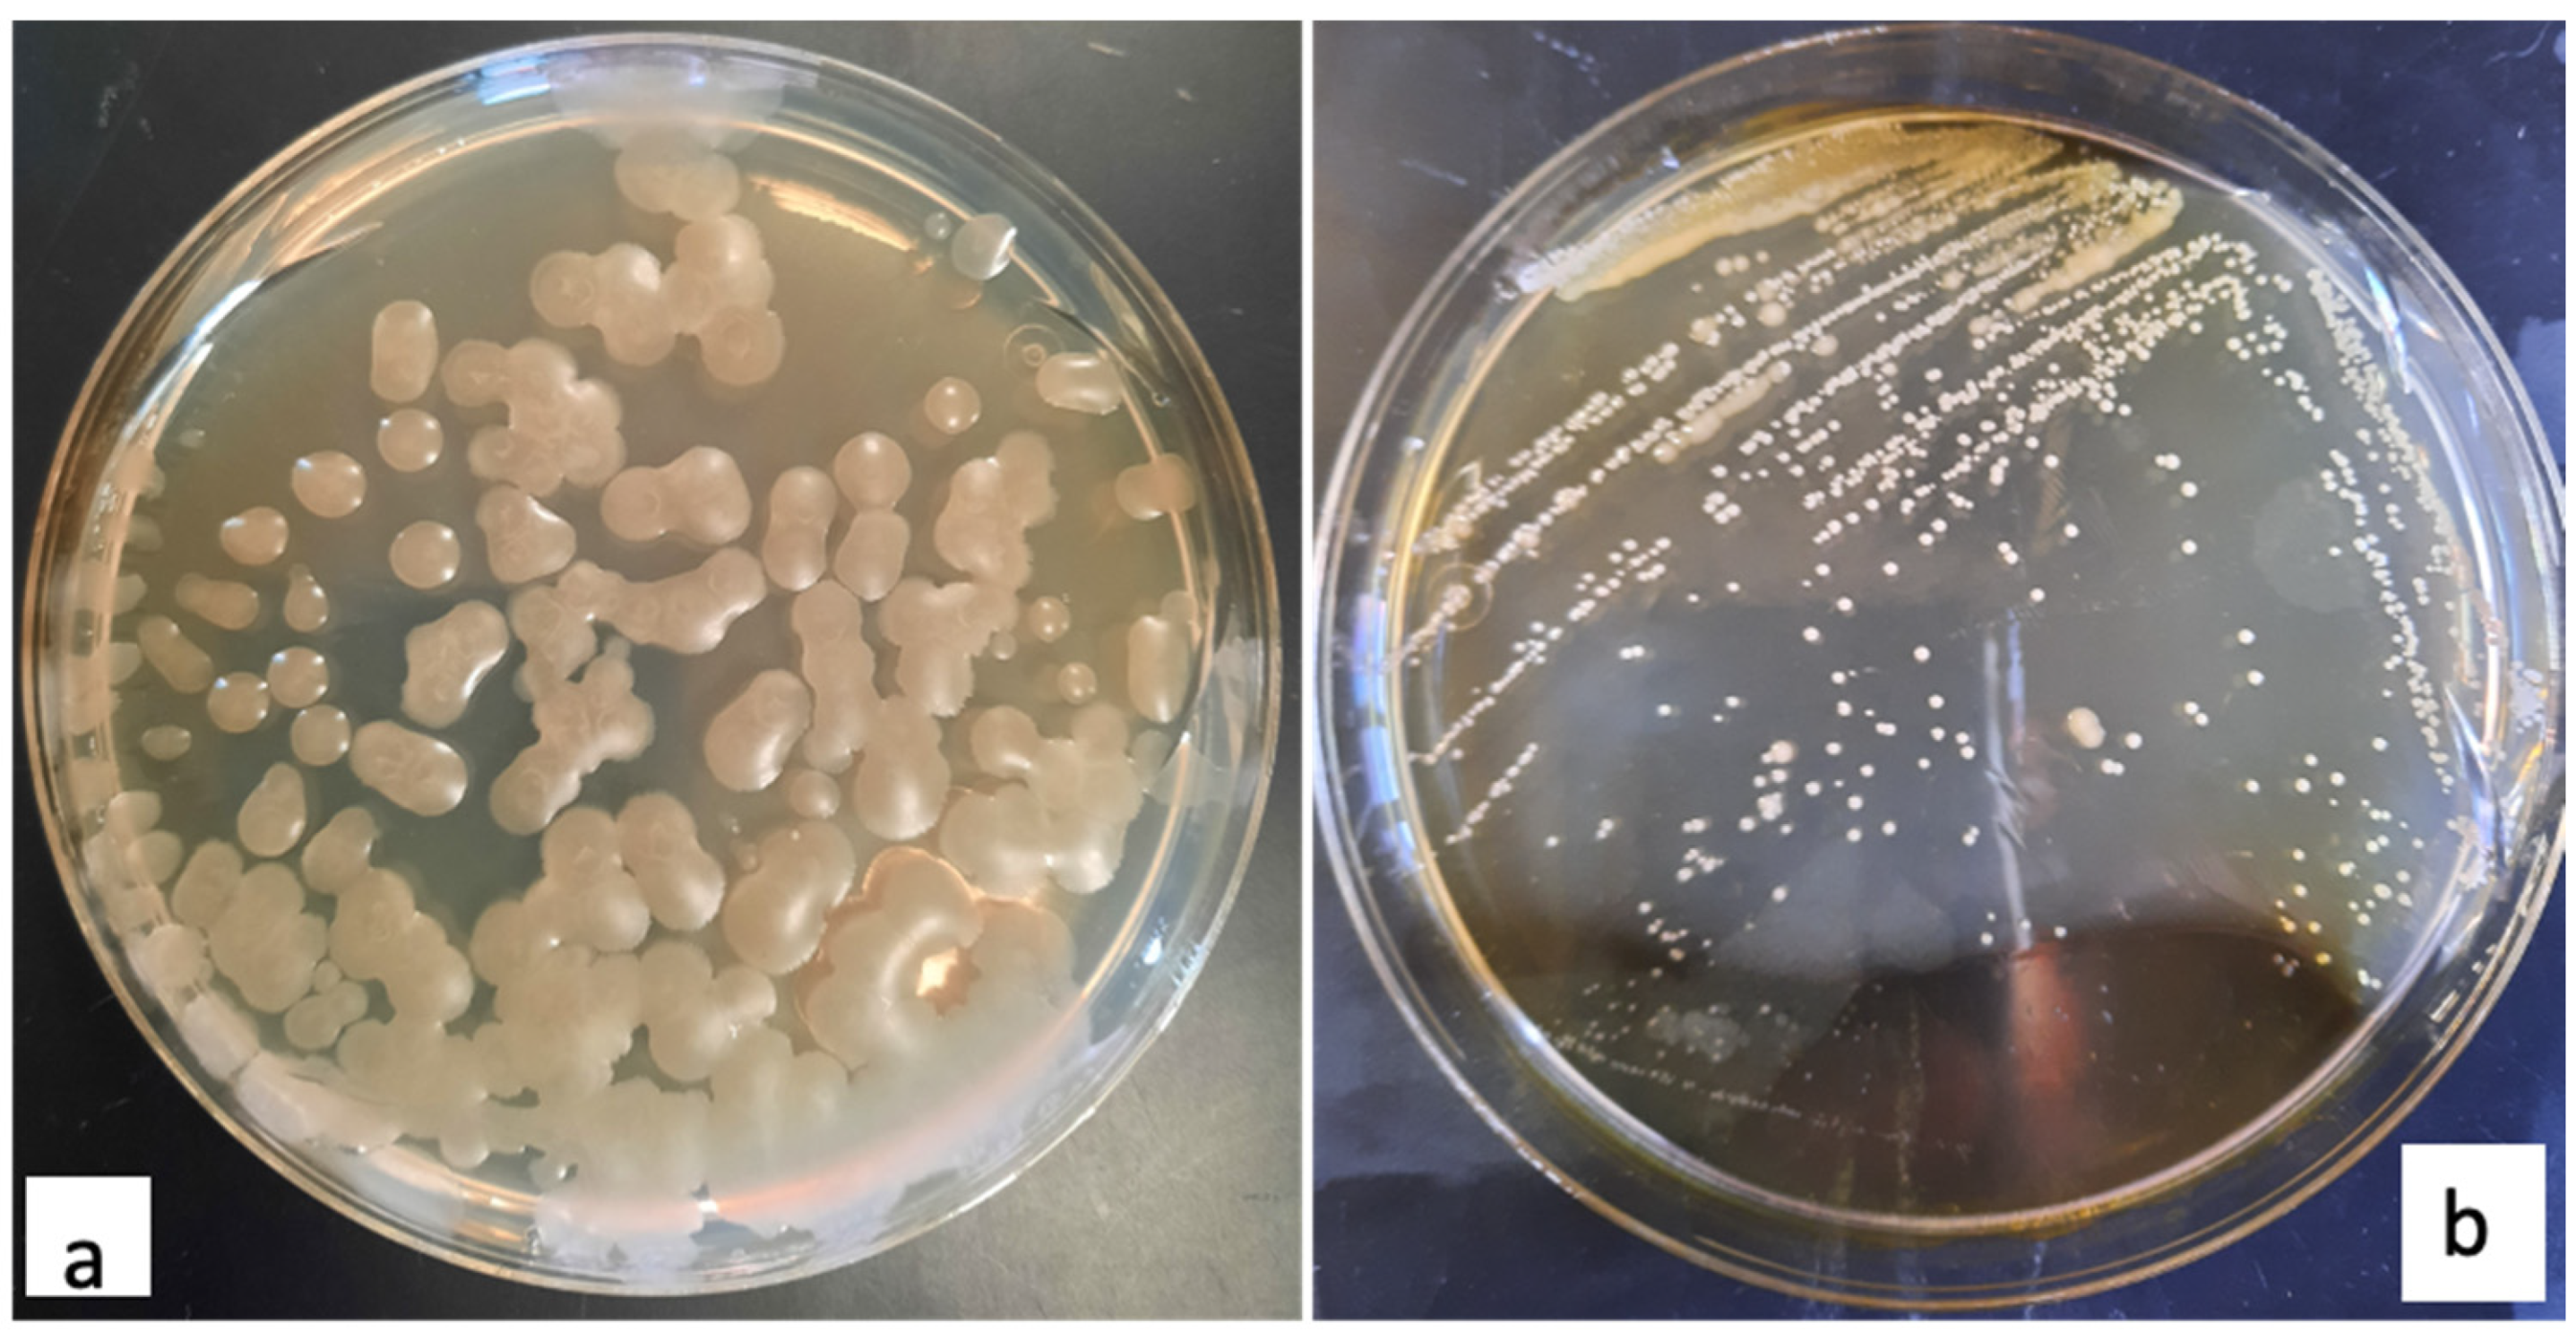
Polymers 13 01870 g005 Polymers 13 01870 g005
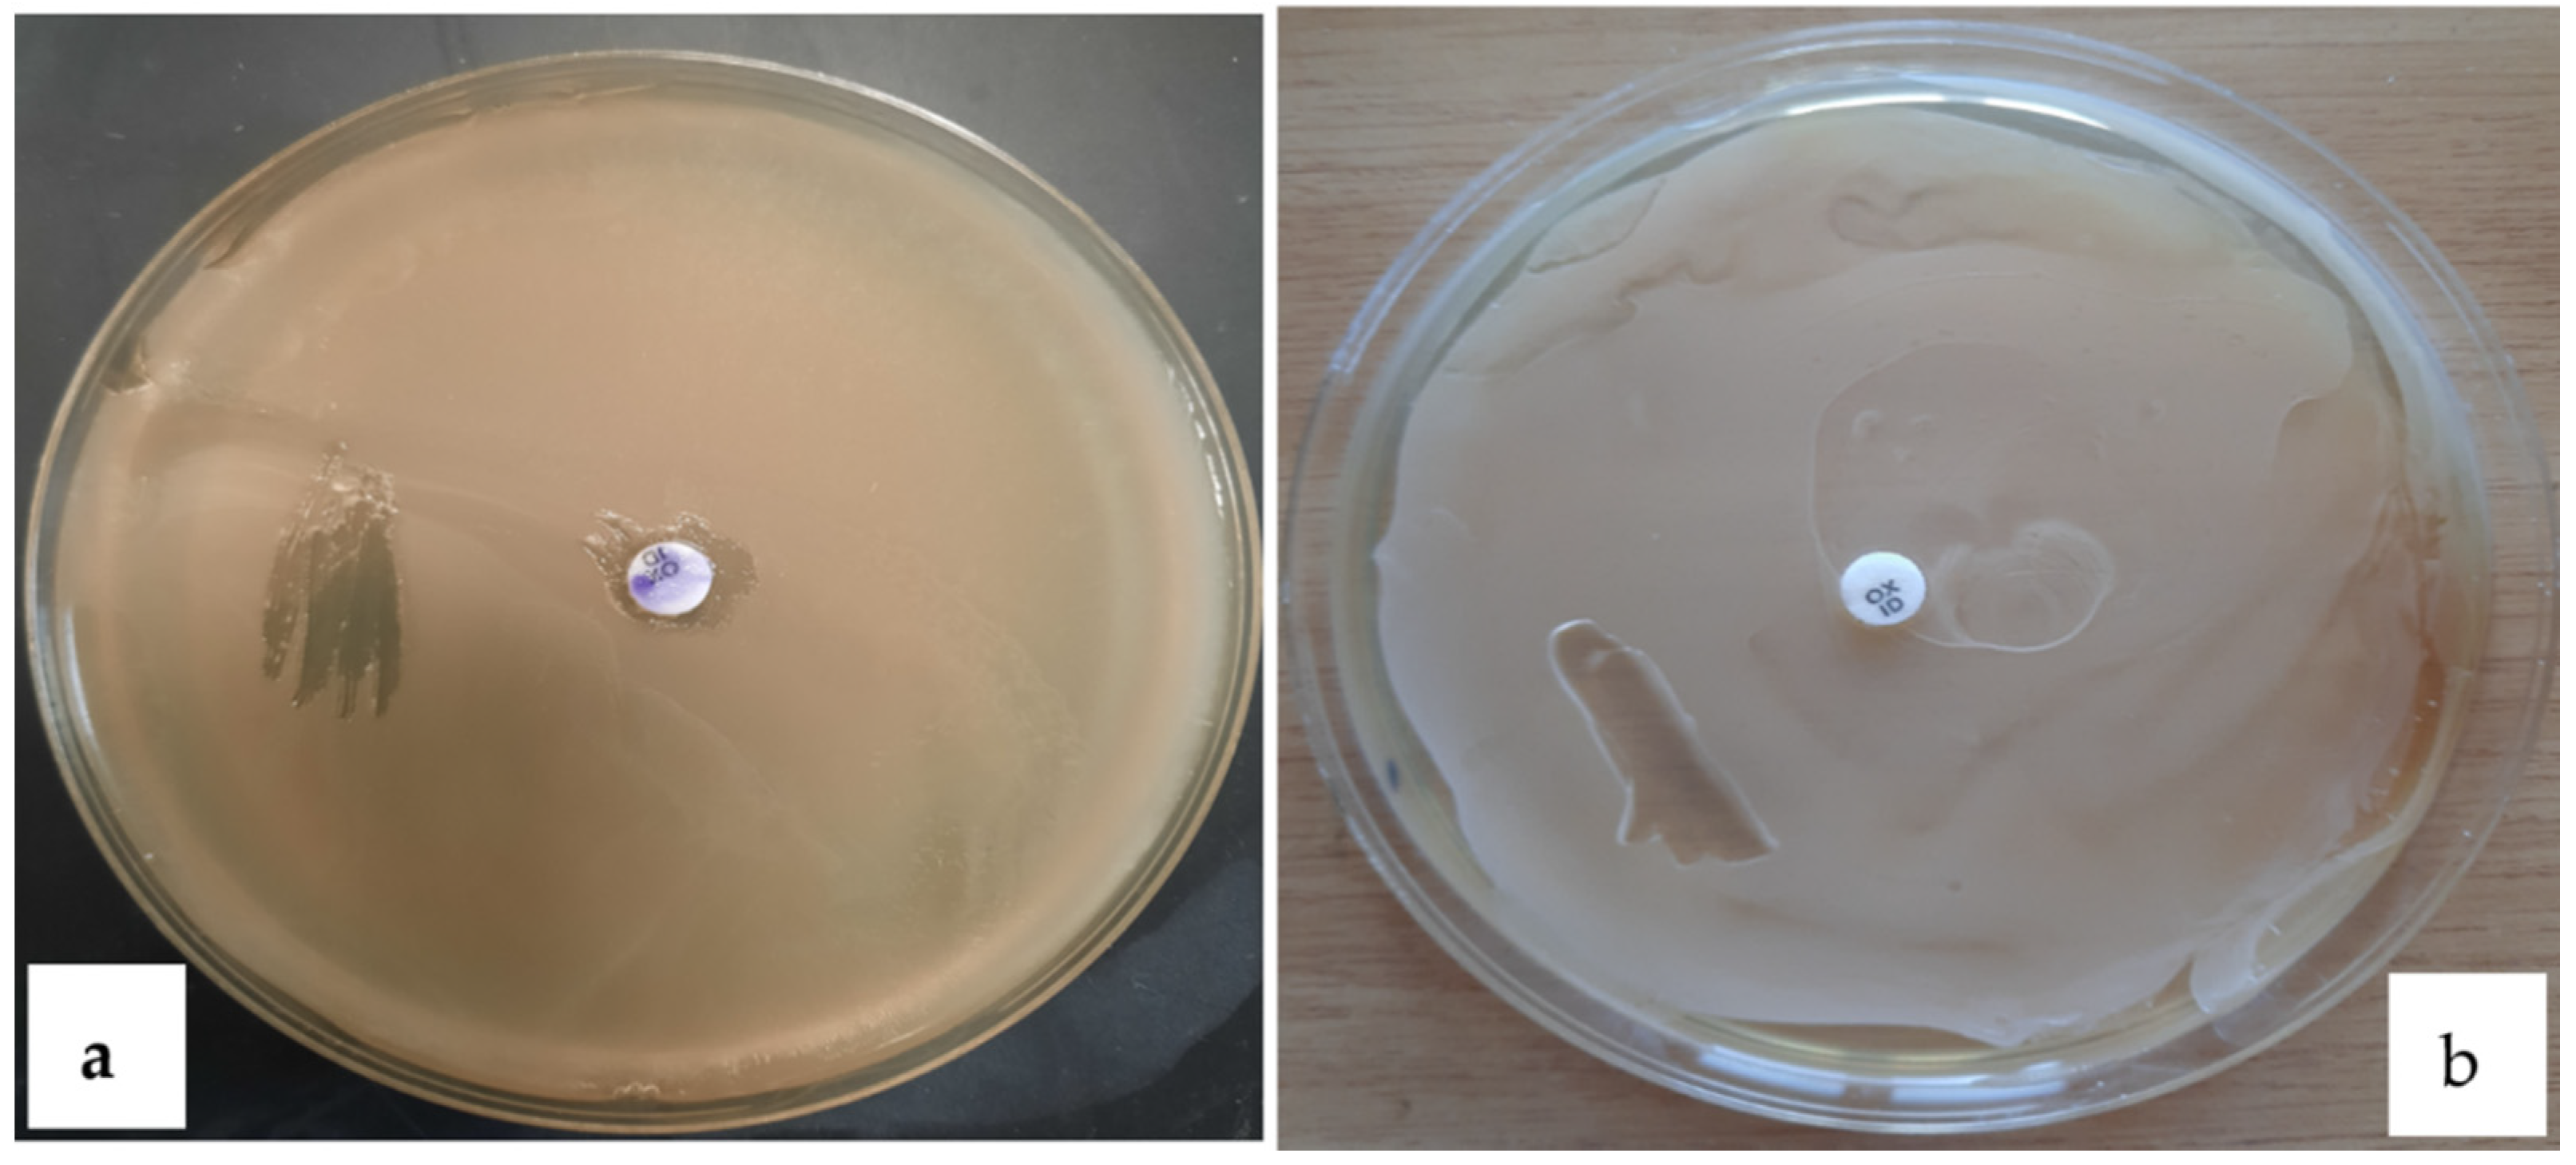
Polymers 13 01870 g009 Polymers 13 01870 g009

Isolation of Two Bacterial Species from Argan Soil in Morocco Associated with Polyhydroxybutyrate (PHB) Accumulation: Current Potential and Future Prospects for the Bio-Based Polymer Production
Abstract
1. Introduction
2. Materials and Methods
2.1. Soil Collection and Isolation of Heat Resistant Bacteria
2.2. Screening for Endospore Forming Bacteria
2.3. Screening for PHB-Producing Bacteria
2.3.1. Sudan Black Staining on Petri Dishes
2.3.2. Sudan Black Staining on Glass Slides
2.4. Morphology and Biochemical Characterization of the Isolates
2.4.1. Morphology and Gram Staining
2.4.2. Biochemical Characterization
2.4.3. Antibiotic Susceptibility
3. Results and Discussion
3.1. Soil Collection and Isolation of Heat Resistant Bacteria
3.2. Screening for Endospore Forming Bacteria
3.3. Screening for PHB-Producing Bacteria
Sudan Black Staining on Petri Dish and Glass Slide
3.4. Morphological and Biochemical Characterization of the Isolates
3.4.1. Morphology and Gram Staining
3.4.2. Biochemical Characterization
3.4.3. Antibiotic Susceptibility
4. Conclusions
Author Contributions
Funding
Institutional Review Board Statement
Informed Consent Statement
Acknowledgments
Conflicts of Interest
Abbreviations
References
- El-Hamshary, O.I.M.; Kadi, H.A.; Al-Twaty, N.H. Molecular Characterization and Uv Improvement of Some Bioplastic-Producing Bacteria Isolated from Plants in Taif City, Saudi Arabia. Pharmacophore 2018, 9, 7–18. [Google Scholar]
- Rathore, P. Bioprospects of PHB: A Review. Int. J. Emerg. Trends Sci. Technol. 2014, 1, 529–532. [Google Scholar]
- Al Battashi, H.; Al-Kindi, S.; Gupta, V.K.; Sivakumar, N. Polyhydroxyalkanoate (PHA) Production Using Volatile Fatty Acids Derived from the Anaerobic Digestion of Waste Paper. J. Polym. Environ. 2021, 29, 250–259. [Google Scholar] [CrossRef]
- Schlebrowski, T.; Ouali, R.; Hahn, B.; Wehner, S.; Fischer, C.B. Comparing the Influence of Residual Stress on Composite Materials Made of Polyhydroxybutyrate (PHB) and Amorphous Hydrogenated Carbon (a-C:H) Layers: Differences Caused by Single Side and Full Substrate Film Attachment During Plasma Coating. Polymers 2021, 13, 184. [Google Scholar] [CrossRef] [PubMed]
- Keskin, G.; Kızıl, G.; Bechelany, M.; Pochat-Bohatier, C.; Öner, M. Potential of polyhydroxyalkanoate (PHA) polymers family as substitutes of petroleum based polymers for packaging applications and solutions brought by their composites to form barrier materials. Pure Appl. Chem. 2017, 89, 1841–1848. [Google Scholar] [CrossRef]
- Elsayed, N.S.; Aboshanab, K.M.; Aboulwafa, M.M.; Hassouna, N.A. Cost-effective production of the bio-plastic poly-beta-hydroxybutyrate using Acinetobacter baumannii isolate P39. J. Microbiol. Biotechnol. Food Sci. 2016, 5, 552–556. [Google Scholar] [CrossRef][Green Version]
- Bugnicourt, E.; Cinelli, P.; Lazzeri, A.; Alvarez, V. Polyhydroxyalkanoate (PHA): Review of synthesis, characteristics, processing and potential applications in packaging. Express Polym. Lett. 2014, 8, 791–808. [Google Scholar] [CrossRef]
- Panigrahi, S.; Badveli, U. Screening, Isolation and Quantification of PHB-Producing Soil Bacteria. Int. J. Eng. Sci. Invent. 2013, 2, 1–6. [Google Scholar]
- Thammasittirong, A.; Saechow, S.; Thammasittirong, S.N.R. Efficient polyhydroxybutyrate production from bacillus thuringiensis using sugarcane juice substrate. Turk. J. Biol. 2017, 41, 992–1002. [Google Scholar] [CrossRef]
- Devi, N.C.; Mazumder, P.B.; Bhattacharjee, A. Statistical Optimization of Polyhydroxybutyrate Production by Bacillus Pumilus H9 Using Cow Dung as a Cheap Carbon Source by Response Surface Methodology. J. Polym. Environ. 2018, 26, 3159–3167. [Google Scholar] [CrossRef]
- Bharti, S.N.; Swetha, G. Need for Bioplastics and Role of Biopolymer PHB: A Short Review. J. Pet. Environ. Biotechnol. 2016, 7, 1–4. [Google Scholar] [CrossRef]
- Obruca, S.; Sedlacek, P.; Krzyzanek, V.; Mravec, F.; Hrubanova, K.; Samek, O.; Kucera, D.; Benesova, P.; Marova, I. Accumulation of Poly(3-hydroxybutyrate) Helps Bacterial Cells to Survive Freezing. PLoS ONE 2016, 11, e0157778. [Google Scholar] [CrossRef] [PubMed]
- Rosli, N.; Ambak, K.; Daniel, B.D.; Prasetijo, J.; Tun, U.; Onn, H.; Pahat, B. Isolation and Characterization of Polyhydroxybutyrate (PHB) Producing Bacteria from Waste Cooking Oil Using Pomegranate Molasses and Carbon Source. J. Teknologi. 2015, 1, 1–6. [Google Scholar]
- Lathwal, P.; Nehra, K.; Singh, M.; Rana, J.S. Characterization of Novel and Efficient Poly-3-hydroxybutyrate (PHB) Producing Bacteria Isolated from Rhizospheric Soils. J. Polym. Environ. 2018, 26, 3437–3450. [Google Scholar] [CrossRef]
- Alshehrei, F. Production of polyhydroxybutyrate (PHB) by bacteria isolated from soil of Saudi Arabia. J. Pure Appl. Microbiol. 2019, 13, 897–904. [Google Scholar] [CrossRef]
- Wani, S.; Sayyed, R.Z. Biopolymers of Microbial Origin. Adv. Physicochem. Prop. Biopolym. 2017, 4, 109–193. [Google Scholar]
- Loo, C.; Sudesh, K. Polyhydroxyalkanoates: Bio-based microbial plastics and their properties. Malays. Polym. J. 2007, 2, 31–57. [Google Scholar]
- Altaee, N.; El-Hiti, G.A.; Fahdil, A.; Sudesh, K.; Yousif, E. Screening and Evaluation of Poly(3-hydroxybutyrate) with Rhodococcus equi Using Different Carbon Sources. Arab. J. Sci. Eng. 2016, 42, 2371–2379. [Google Scholar] [CrossRef]
- Karim, F.; Mumtaz, T.; Fakhruddin, A.N.M. Isolation and screening of biopolyester producing bacteria from compost samples in Bangladesh. J. Biosci. Biotechnol. 2018, 7, 23–29. [Google Scholar]
- López, J.A.; Naranjo, J.M.; Higuita, J.C.; Cubitto, M.A.; Cardona, C.A.; Villar, M.A. Biosynthesis of PHB from a new isolated Bacillus megaterium strain: Outlook on future developments with endospore forming bacteria. Biotechnol. Bioprocess Eng. 2012, 17, 250–258. [Google Scholar] [CrossRef]
- Hussey, M.A. Endospore Stain Protocol. Am. Soc. Microbiol. 2013, 1–11. [Google Scholar]
- Kane, S.N.; Mishra, A.; Dutta, A.K. Preface: International Conference on Recent Trends in Physics (ICRTP 2016). J.Phys. Conf. Ser. 2016, 755, 3–8. [Google Scholar]
- Thapa, C.; Shakya, P.; Shrestha, R.; Pal, S.; Manandhar, P. Isolation of Polyhydroxybutyrate (PHB) Producing Bacteria, Optimization of Culture Conditions for PHB production, Extraction and Characterization of PHB. Nepal J. Biotechnol. 2019, 6, 62–68. [Google Scholar] [CrossRef]
- Madhumathi, R.; Velan, M. Isolation, screening and selection of efficient polyhydroxybutyrate (PHB) synthesizing bacteria. J. Pure Appl. Microbiol. 2016, 10, 677–683. [Google Scholar]
- Reddy, A.R.; Kumar, R.B.; Prabhakar, K.V. Isolation and Identification of PolyHydroxyButyrate (PHB) producing bacteria from Sewage sample. Res. J. Pharm. Technol. 2017, 10, 1065. [Google Scholar] [CrossRef]
- Bryan, M.; Robison, R.; Woolverton, C. Colony Morphology Protocol—Library. Am. Soc. Microbiol. 2013, 1–4. [Google Scholar]
- Smith, A.C.; Hussey, M.A. Gram stain protocols. Am. Soc. Microbiol. 2005, 1, 14. [Google Scholar]
- Hudzicki, J. Kirby-Bauer Disk Diffusion Susceptibility Test Protocol Author Information. Am. Soc. Microbiol. 2012, 1–13. [Google Scholar]
- Bhuwal, A.K.; Singh, G.; Aggarwal, N.K.; Goyal, V.; Yadav, A. Isolation and Screening of Polyhydroxyalkanoates Producing Bacteria from Pulp, Paper, and Cardboard Industry Wastes. Int. J. Biomater. 2013, 2013, 1–10. [Google Scholar] [CrossRef]
- Lugg, H.; Sammons, R.L.; Marquis, P.M.; Hewitt, C.J.; Yong, P.; Paterson-Beedle, M.; Redwood, M.D.; Stamboulis, A.; Kashani, M.; Jenkins, M.; et al. Polyhydroxybutyrate accumulation by a Serratia sp. Biotechnol. Lett. 2007, 30, 481–491. [Google Scholar] [CrossRef]
- Gupta, A.; Kumar, M.; Thakur, I.S. Analysis and optimization of process parameters for production of polyhydroxyalkanoates along with wastewater treatment by Serratia sp. ISTVKR1. Bioresour. Technol. 2017, 242, 55–59. [Google Scholar] [CrossRef] [PubMed]
- Patel, S.K.; Kumar, P.; Singh, M.; Lee, J.-K.; Kalia, V.C. Integrative approach to produce hydrogen and polyhydroxybutyrate from biowaste using defined bacterial cultures. Bioresour. Technol. 2015, 176, 136–141. [Google Scholar] [CrossRef] [PubMed]
- Stock, I.; Burak, S.; Sherwood, K.J.; Grüger, T.; Wiedemann, B. Natural antimicrobial susceptibilities of strains of “unusual” Serratia species: S. ficaria, S. fonticola, S. odorifera, S. plymuthica and S. rubidaea. J. Antimicrob. Chemother. 2003, 51, 865–885. [Google Scholar] [CrossRef] [PubMed]
- Stock, I. Natural antibiotic susceptibility of Proteus spp., with special reference to P. mirabilis and P. penneri strains. J. Chemother. 2003, 15, 12–26. [Google Scholar] [CrossRef] [PubMed]

| Morphology | 1B Strain | 2D1 Strain |
|---|---|---|
| shape | regular, entire, spherical, large | regular, entire, sherical, small |
| margin | regular | regular |
| color | white | white |
| opacity | translucent | translucent |
| elevation | convex | droplike |
| size (diameter) | 3–5 mm | 0.5–1 mm |
| surface | smooth, glisterine | smooth, glisterine |
| texture | moist, viscid | dry |
| arrangement | clustered | isolated |
| Biochemical Tests | 1B Strain | 2D1 Strain |
|---|---|---|
| beta galactosidase | + | - |
| arginine decarboxylase | - | - |
| lysine decarboxylase | - | - |
| ornithine decarboxylase | - | - |
| citrate | - | - |
| hydrogen sulfite production | - | - |
| urease | - | + |
| tryptophane deaminase | - | - |
| indole test | - | - |
| Voges Proskauer | - | - |
| gelatinase presence | + | + |
| glucose fermentation | + | + |
| mannose fermentation | + | - |
| inositol fermentation | + | - |
| sorbitol fermentation | + | - |
| rhamnose fermentation | - | - |
| sucrose fermentation | + | + |
| melibiose fermentation | - | - |
| amygdalin fermentation | + | - |
| arabinose fermentation | + | - |
| oxidase test | - | - |
| lactose | + | - |
| maltose | + | + |
| fructose | + | + |
| galactose | - | - |
| dulcitol | - | - |
| starch | - | - |
| Probable genus | Serratia | Proteus |
| Antibiotic | Symbol | Concentration (μg) | 1B Genus Serratia | 2D1 Genus Proteus |
|---|---|---|---|---|
| amoxicillin | AML | 2 | resistant | resistant |
| cefepime | FEP | 30 | resistant | resistant |
| ampic/sulbac | SAM | 20 | resistant | resistant |
| penicilline G | P | 10 | resistant | resistant |
| imipenem | IPM | 10 | resistant | resistant |
| roxithromocyn | RXT | 15 | resistant | resistant |
| floxapen | FU | 5 | resistant | resistant |
| gentamicin | CN | 10 | intermediate | intermediate |
| chloramphenicol | C | 30 | susceptible | susceptible |
| bacitracin | B | 10 | resistant | intermediate |
| ampic/clav acid | AMC | 30 | resistant | intermediate |
| kanamycin | K | 30 | susceptible | susceptible |
| nitroxoline | NI | 20 | susceptible | susceptible |
| flumequine | AR | 30 | susceptible | susceptible |
| teicoplanin | TEC | 30 | resistant | intermediate |
Publisher’s Note: MDPI stays neutral with regard to jurisdictional claims in published maps and institutional affiliations. |
© 2021 by the authors. Licensee MDPI, Basel, Switzerland. This article is an open access article distributed under the terms and conditions of the Creative Commons Attribution (CC BY) license (https://creativecommons.org/licenses/by/4.0/).
Share and Cite
Aragosa, A.; Specchia, V.; Frigione, M. Isolation of Two Bacterial Species from Argan Soil in Morocco Associated with Polyhydroxybutyrate (PHB) Accumulation: Current Potential and Future Prospects for the Bio-Based Polymer Production. Polymers 2021, 13, 1870. https://doi.org/10.3390/polym13111870
Aragosa A, Specchia V, Frigione M. Isolation of Two Bacterial Species from Argan Soil in Morocco Associated with Polyhydroxybutyrate (PHB) Accumulation: Current Potential and Future Prospects for the Bio-Based Polymer Production. Polymers. 2021; 13(11):1870. https://doi.org/10.3390/polym13111870
Chicago/Turabian StyleAragosa, Amina, Valeria Specchia, and Mariaenrica Frigione. 2021. "Isolation of Two Bacterial Species from Argan Soil in Morocco Associated with Polyhydroxybutyrate (PHB) Accumulation: Current Potential and Future Prospects for the Bio-Based Polymer Production" Polymers 13, no. 11: 1870. https://doi.org/10.3390/polym13111870
APA StyleAragosa, A., Specchia, V., & Frigione, M. (2021). Isolation of Two Bacterial Species from Argan Soil in Morocco Associated with Polyhydroxybutyrate (PHB) Accumulation: Current Potential and Future Prospects for the Bio-Based Polymer Production. Polymers, 13(11), 1870. https://doi.org/10.3390/polym13111870

